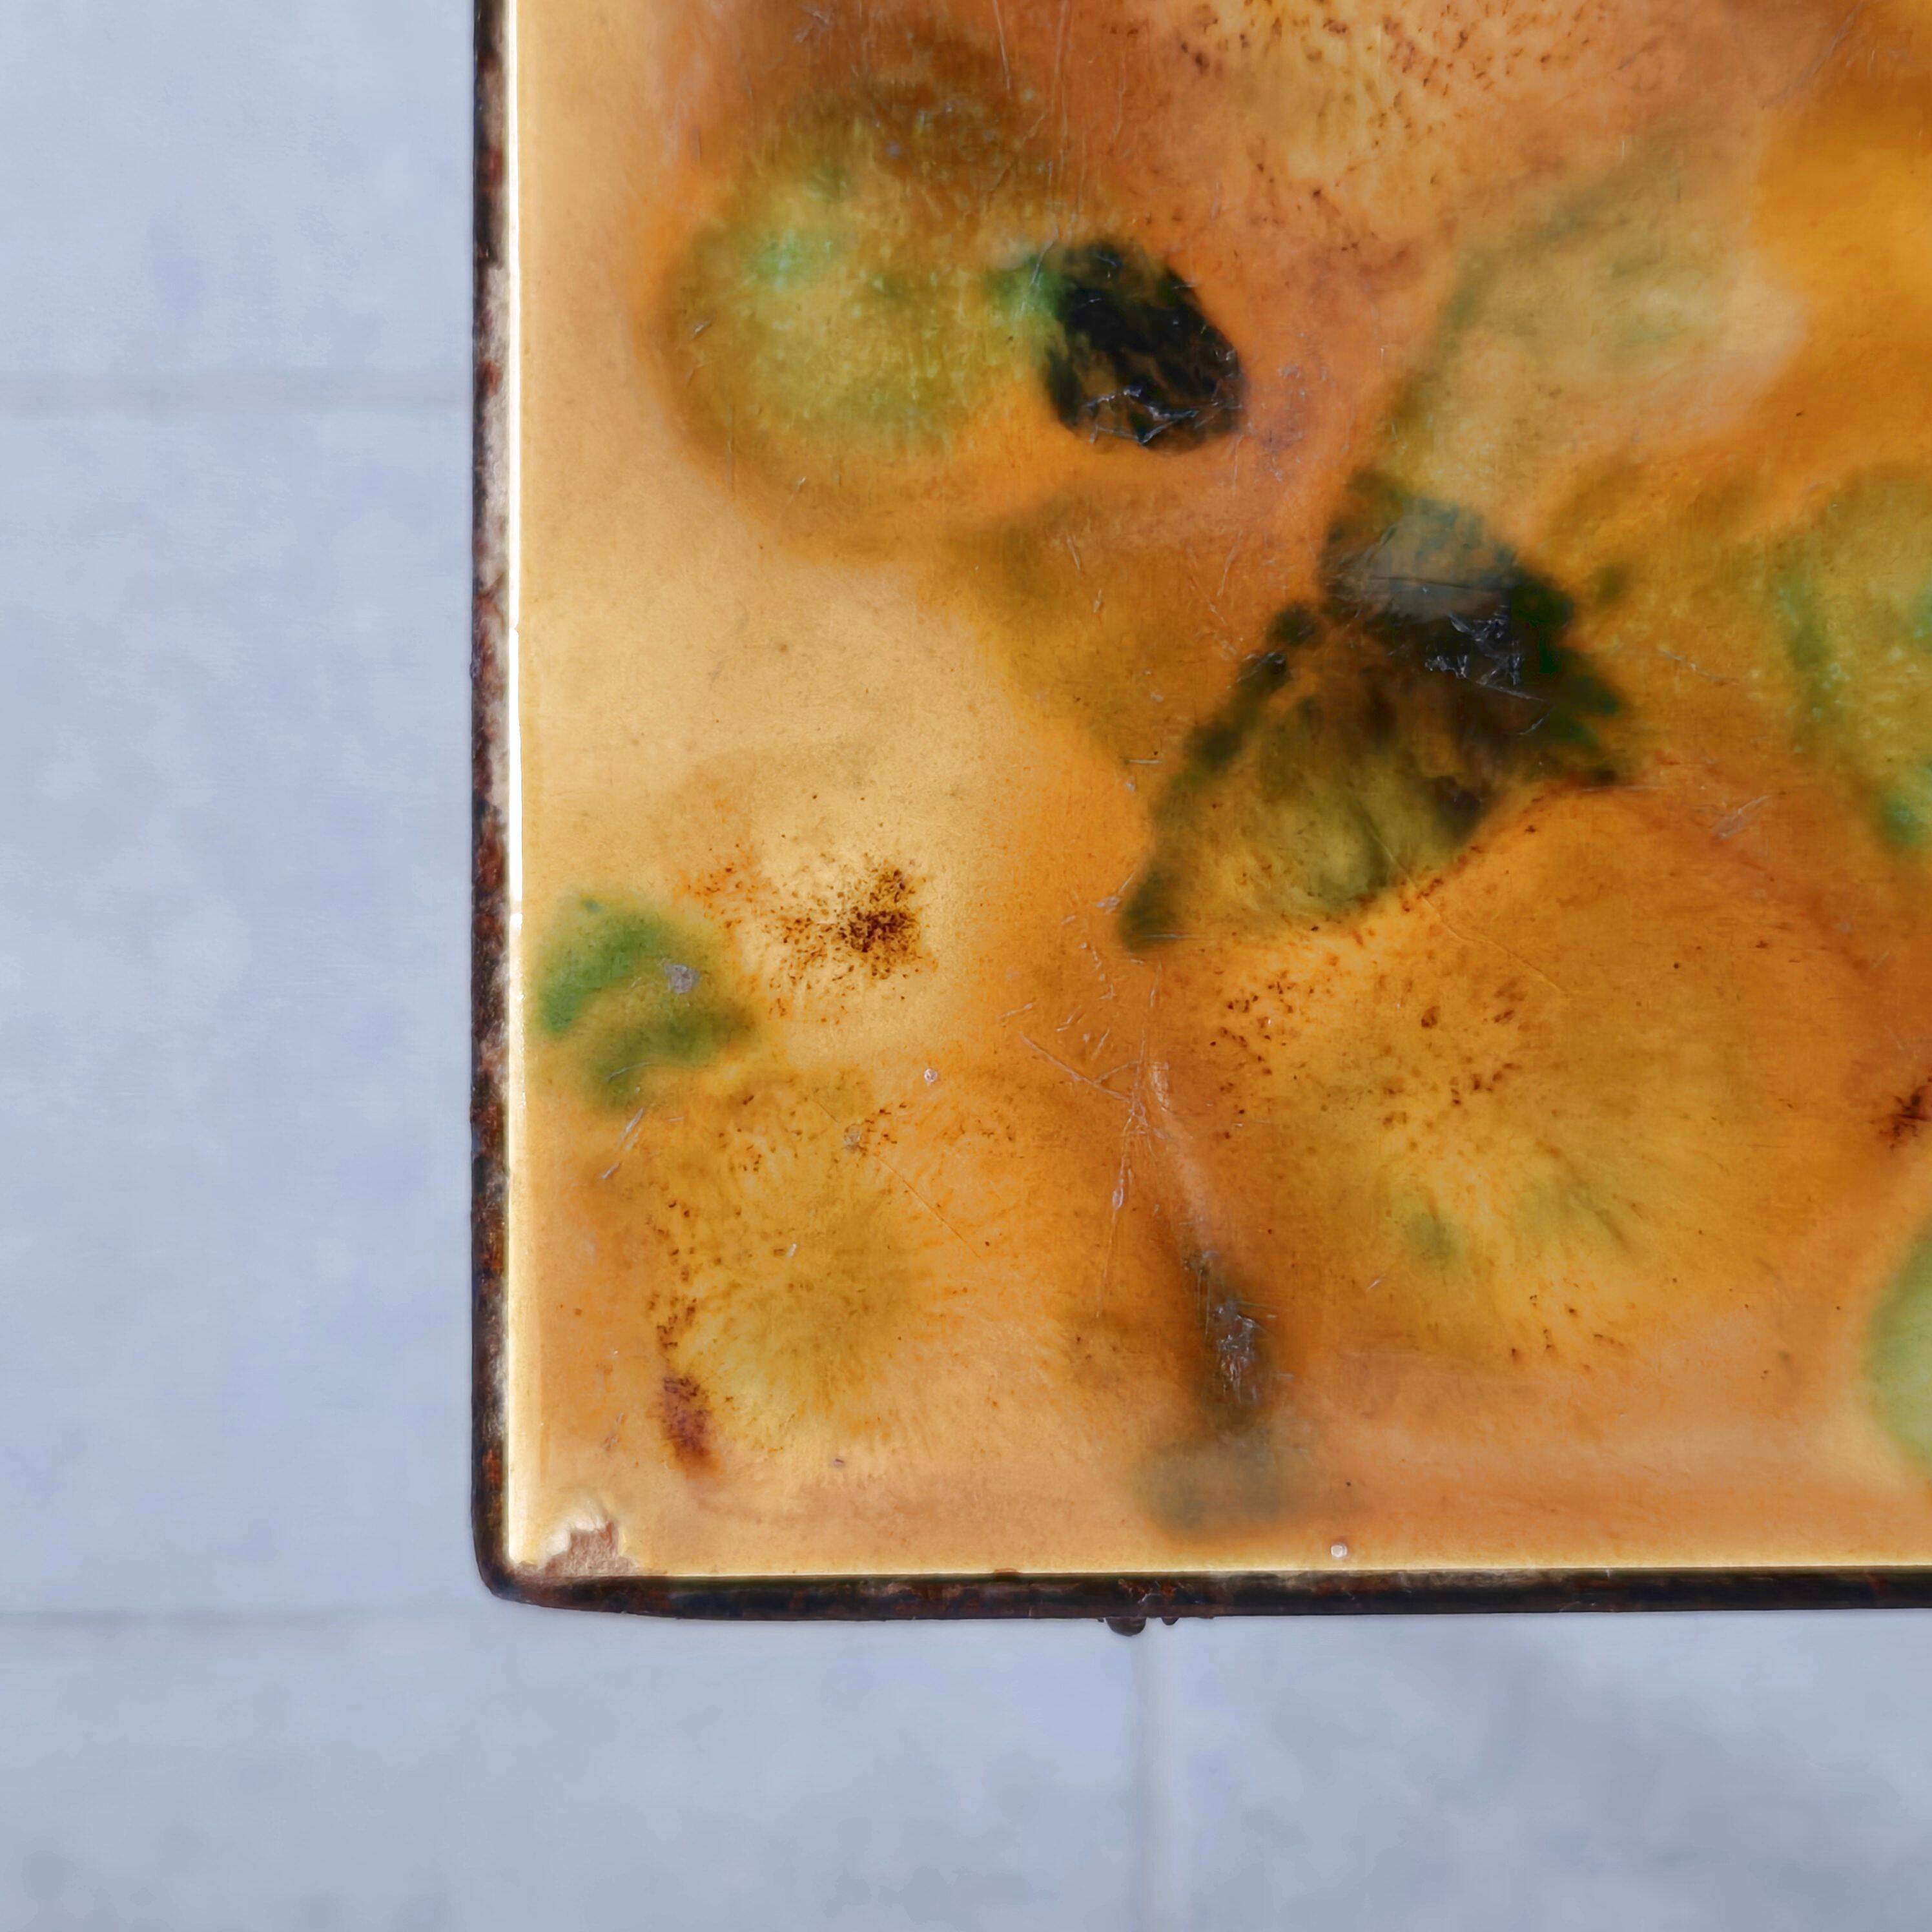
Vintage side table 1960

Page 1 of 17
Vintage side table 1960
€182

Vintage side table 1960
€182
- Dimensions :
- H38 x W46 x D31
- Color :
- yellow
- Material :
- ceramics, porcelain and earthenware
- Style :
- vintage
Fair condition, chips on the edge of the ceramic tiles, especially on the corners. The metal is oxidized. The rubber feet are new. Height 38.5 cm. Length 46 cm. Width 31 cm. Very nice vintage side table.